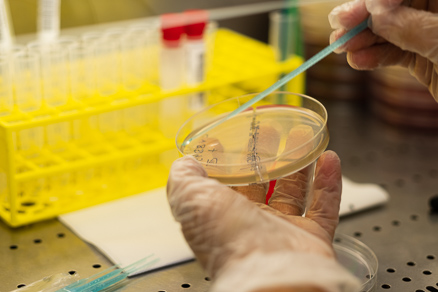
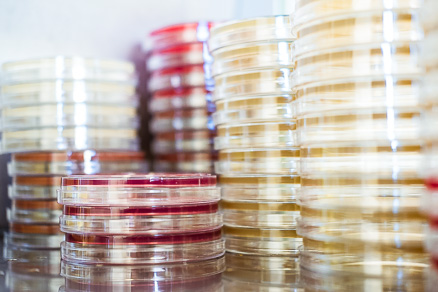

Laboratório Cintramédica
uma referência em saúde
uma referência em saúde
A Cintramédica é o grupo de Saúde referência na região de Sintra, não só por reunir várias clínicas e postos de colheitas em vários concelhos circundantes, mas também ao nível dos exames complementares de diagnóstico.
O Laboratório de Análises Clínicas da Cintramédica é uma das áreas mais importantes e mais desenvolvidas da empresa. Destaca-se pelos seus mais de 40 anos de experiência, pela elevada qualidade dos resultados, e em especial pela facilidade de comunicação com os médicos e os especialistas de diagnóstico, uma vez que o laboratório se encontra incorporado na principal clínica do grupo, em Sintra.
Esse facto permite ter acesso imediato às amostras de sangue processadas no Laboratório de Análises Clínicas, tornando possível responder todos os dias, de forma rápida e eficiente, tanto aos pedidos de análises de rotina como a todas as urgências.
O Laboratório de Análises Clínicas da Cintramédica também é o único no concelho de Sintra que está certificado com o nível de Biossegurança 2, permitindo o manejo de agentes patogénios como o vírus do SARS-CoV-2.
O Laboratório de Análises Clínicas da Cintramédica é uma das áreas mais importantes e mais desenvolvidas da empresa. Destaca-se pelos seus mais de 40 anos de experiência, pela elevada qualidade dos resultados, e em especial pela facilidade de comunicação com os médicos e os especialistas de diagnóstico, uma vez que o laboratório se encontra incorporado na principal clínica do grupo, em Sintra.
Esse facto permite ter acesso imediato às amostras de sangue processadas no Laboratório de Análises Clínicas, tornando possível responder todos os dias, de forma rápida e eficiente, tanto aos pedidos de análises de rotina como a todas as urgências.
O Laboratório de Análises Clínicas da Cintramédica também é o único no concelho de Sintra que está certificado com o nível de Biossegurança 2, permitindo o manejo de agentes patogénios como o vírus do SARS-CoV-2.
Postos de Colheita
As suas análises mais perto de si
A equipa do Laboratório de Análises Clínicas da Cintramédica dá resposta, todos os dias, a centenas de amostras de sangue provenientes não só da clínica de Sintra, onde está localizado o laboratório, mas também das sete clínicas e treze postos de colheita Cintramédica espalhadas por quatro concelhos da região de Lisboa. Graças a uma equipa de excelência e a equipamento de última geração, todas as amostras são analisadas com eficiência e foco na rapidez dos resultados de modo a permitirem um diagnóstico eficaz. Além do envio por SMS ou email, os resultados das análises realizadas ficam ainda acessíveis online no Portal Cintramédica.
SAIBA MAIS
SAIBA MAIS
Análises especiais
Diagnóstico de qualidade
O Laboratório de Análises Clínicas da Cintramédica tem ao seu serviço inúmeros testes de diagnóstico para várias fases da vida. Desde o despiste das trissomias mais comuns a testes de intolerância alimentar e perfil genético, ou os exames de diagnóstico e serológicos que lhe permitem ficar a saber se está ou já esteve infetado com o vírus SARS-CoV-2.
SABER MAIS
SABER MAIS
Qualidade certificada
O Laboratório de Análises Clínicas da Cintramédica é uma unidade certificada pela norma ISO:9OO1 que reconhece o Sistema de Gestão da Qualidade do laboratório. A qualidade das análises clínicas realizadas na Cintramédica é ainda sujeita a um rigoroso controlo interno e a programas de Avaliação Externa da Qualidade.
NP EN ISO:9001
- Certificação desde 2014
- Auditado periodicamente pela APCER
- Norma vigente no laboratório central e postos de colheitas
Controlo rigoroso
- Programas de controlo de qualidade internos
- Programas de Avaliação Externa da Qualidade nacionais e internacionais com excelente desempenho analítico
SAIBA MAIS








Uma equipa de Confiança
As suas análises nas mãos de quem você conhece e confia
A equipa do Laboratório construiu, ao longo dos anos, uma relação de confiança e proximidade com os habitantes da região de Sintra, tornando-se assim uma referência em saúde no Concelho.
Profissionais

Dr. Carlos Marques
Diretor Técnico

Dra. Inês Marques Stilwell
Coordenadora Laboratório de Análises Clínicas

Ângela Caminho
Coordenadora Atendimento ao Cliente Laboratório Análises Clínicas

Lígia Nascimento
Coordenadora de Colheitas de Análises Clínicas

_b1_14_101B7F64-82A6.jpg)
















